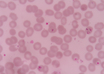

Anabolic steroids may raise risk of premature death in men
IANS | Nov 23, 2018
Scientists identify patients resistant to last-line malaria drug
The Telegraph | Nov 22, 2018
98 million Indians may have diabetes by 2030: Lancet study
PTI | Nov 22, 2018
Spinning charkha may have positive effect on mental health: Study
PTI | Nov 21, 2018
Depressed people may have poor blood flow
ANI | Nov 21, 2018
Clinical trial finds new immunotherapy improves MS symptoms
ANI | Nov 21, 2018
New drug shows promise in halting spread of brain cancer
IANS | Nov 21, 2018
New treatment shows promise against peanut allergy: NEJM
IANS | Nov 21, 2018
New dual-action virus effective in treating cancer
IANS | Nov 21, 2018
World's first total-body scanner produces incredible 3D images
IANS | Nov 21, 2018
Most read this week